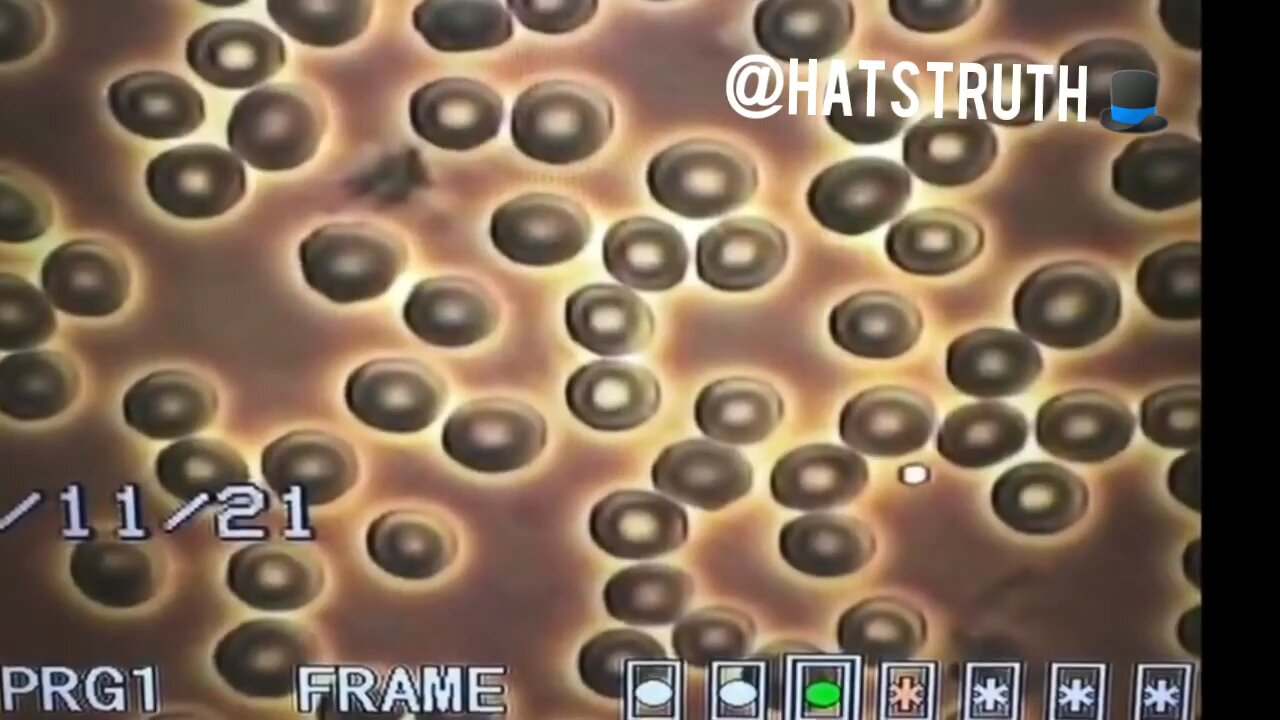
Jab aftermath

Premium Only Content
This video is only available to Rumble Premium subscribers. Subscribe to
enjoy exclusive content and ad-free viewing.
Jab aftermath
Loading comments...
-
 LIVE
LIVE
Lofi Girl
2 years agoSynthwave Radio 🌌 - beats to chill/game to
181 watching -
 7:40
7:40
Blabbering Collector
11 hours agoLEAKED: Draco Malfoy, Hooch, Neville Longbottom! | Harry Potter HBO Show Update, Wizarding News
711 -
 3:06:35
3:06:35
Badlands Media
15 hours agoDEFCON ZERQ Ep. 017: Tesla Tech, Ancient Power & The Fight for Human Consciousness
211K51 -
 3:11:56
3:11:56
TimcastIRL
7 hours agoDOJ Launches FULL INVESTIGATION Into TPUSA Antifa RIOT, Media Says Mostly Peaceful | Timcast IRL
249K77 -
 3:16:27
3:16:27
Barry Cunningham
11 hours agoBREAKING NEWS: SOLVING THE HOUSING CRISIS BY UNDERSTANDING VETERANS DAY! AND IT'S MOVIE NIGHT!
76.7K32 -
 8:58:17
8:58:17
SpartakusLIVE
9 hours agoWZ Solos to Start || NEW Battlefield 6 - REDSEC Update Later
22.4K1 -
 1:01:56
1:01:56
ThisIsDeLaCruz
17 hours ago $9.81 earnedInside Kenny Chesney’s Sphere Part 1: Exclusive Backstage Pass
34.4K2 -
 2:09:50
2:09:50
DLDAfterDark
6 hours ago $2.41 earnedA Complete Look Into The Glock "V Series"! Pistol In Hand! VERY GAY!!
19.6K2 -
 7:42
7:42
China Uncensored
14 hours agoIndia Has Surpassed China
42.9K17 -
 8:47
8:47
Hollywood Exposed
12 hours agoJoe Rogan and Zachary Levi DESTROY Gavin Newsom’s Lies About California
26.3K6